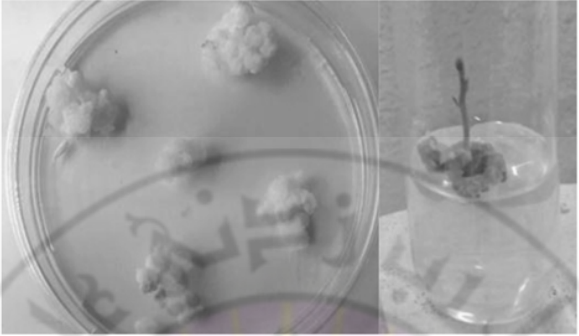

الفاكهة والاشجار المثمرة


نخيل التمر

النخيل والتمور

آفات وامراض النخيل وطرق مكافحتها

التفاح

الرمان

التين

اشجار القشطة

الافو كادو او الزبدية

البشمله او الاكي دنيا

التوت

التين الشوكي

الجوز

الزيتون

السفرجل

العنب او الكرمة

الفستق

الكاكي او الخرما او الخرمالو

الكمثري(الاجاص)

المانجو

الموز

النبق او السدر

فاكة البابايا او الباباظ

الكيوي


الحمضيات

آفات وامراض الحمضيات

مقالات منوعة عن الحمضيات


الاشجار ذات النواة الحجرية

الاجاص او البرقوق

الخوخ او الدراق

الكرز

المشمش

مواضيع عامة

اللوز

الفراولة او الشليك

الجوافة

الخروب(الخرنوب)

الاناناس

مواضيع متنوعة عن اشجار الفاكهة

التمر هندي

الكستناء

شجرة البيكان ( البيقان )

البندق


المحاصيل


المحاصيل البقولية

الباقلاء (الفول)

الحمص

الترمس

العدس

الماش

اللوبياء

الفاصولياء

مواضيع متنوعة عن البقوليات

فاصوليا الليما والسيفا

محاصيل الاعلاف و المراعي


محاصيل الالياف

القطن

الكتان

القنب

الجوت و الجلجل

محصول الرامي

محصول السيسال

مواضيع متنوعة عن محاصيل الألياف


محاصيل زيتية

السمسم

فستق الحقل

فول الصويا

عباد الشمس (دوار الشمس)

العصفر (القرطم)

السلجم ( اللفت الزيتي )

مواضيع متنوعة عن المحاصيل الزيتية

الخروع


محاصيل الحبوب

الذرة

محصول الرز

محصول القمح

محصول الشعير

الشيلم

الشوفان (الهرطمان)

الدخن


محاصيل الخضر

الباذنجان

الطماطم

البطاطس(البطاطا)

محصول الفلفل

محصول الخس

البصل

الثوم


القرعيات

الخيار

الرقي (البطيخ الاحمر)

البطيخ

آفات وامراض القرعيات

مواضيع متنوعة عن القرعيات

البازلاء اوالبسلة

مواضيع متنوعة عن الخضر

الملفوف ( اللهانة او الكرنب )

القرنبيط او القرنابيط

اللفت ( الشلغم )

الفجل

السبانخ

الخرشوف ( الارضي شوكي )

الكرفس

القلقاس

الجزر

البطاطا الحلوه

القرع

الباميه

البروكلي او القرنابيط الأخضر

البنجر او الشمندر او الشوندر

عيش الغراب او المشروم او الأفطر


المحاصيل المنبهة و المحاصيل المخدرة

مواضيع متنوعة عن المحاصيل المنبهة

التبغ

التنباك

الشاي

البن ( القهوة )


المحاصيل السكرية

قصب السكر

بنجر السكر

مواضيع متنوعة عن المحاصيل


نباتات الزينة والنباتات الطبية والعطرية

نباتات الزينة

النباتات الطبية والعطرية


الحشرات النافعة


النحل

نحل العسل

عسل النحل ومنتجات النحل الاخرى

آفات وامراض النحل


دودة القز(الحرير)

آفات وامراض دودة الحرير

تربية ديدان الحرير وانتاج الحرير الطبيعي


تقنيات زراعية

الاسمدة

الزراعة العضوية

الزراعة النسيجية

الزراعة بدون تربة

الزراعة المحمية

المبيدات الزراعية

انظمة الري الحديثة


التصنيع الزراعي

تصنيع الاعلاف

صناعات غذائية

حفظ الاغذية


الانتاج الحيواني


الطيور الداجنة

الدواجن

دجاج البيض

دجاج اللحم

امراض الدواجن


الاسماك

الاسماك

الامراض التي تصيب الاسماك


الابقار والجاموس

الابقار

الجاموس

امراض الابقار والجاموس


الاغنام

الاغنام والماعز

الامراض التي تصيب الاغنام والماعز


آفات وامراض النبات وطرق مكافحتها


الحشرات

الحشرات الطبية و البيطرية

طرق ووسائل مكافحة الحشرات

الصفات الخارجية والتركيب التشريحي للحشرات

مواضيع متنوعة عن الحشرات

انواع واجناس الحشرات الضارة بالنبات

المراتب التصنيفية للحشرات


امراض النبات ومسبباتها

الفطريات والامراض التي تسببها للنبات

البكتريا والامراض التي تسببها للنبات

الفايروسات والامراض التي تسببها للنبات

الاكاروسات (الحلم)

الديدان الثعبانية (النيماتودا)

امراض النبات غير الطفيلية (الفسيولوجية) وامراض النبات الناتجة عن بعض العناصر

مواضيع متنوعة عن امراض النبات ومسبباتها


الحشائش والنباتات الضارة

الحشائش والنباتات المتطفلة

طرق ووسائل مكافحة الحشائش والنباتات المتطفلة

آفات المواد المخزونة

مواضيع متنوعة عن آفات النبات

المكائن والالات الزراعية

مواضيع متنوعة عن الزراعة
إنتاج سلالات متباينة وراثيا بزراعة الكالوس
المؤلف:
د. خليل المعري
المصدر:
زراعة الانسجة النباتية وتقاناتها -الجزء النظري-
الجزء والصفحة:
ص 209-223
2023-04-25
2963
إنتاج سلالات متباينة وراثيا بزراعة الكالوس
Somaclonal variation by callus culture
يتم الحصول على الكالوس من أجزاء نباتية مختلفة خلايا، فلقات، أوراق، جذور، قمم نامية وبراعم جانبية، حبوب لقاح، أجزاء زهرية، بروتوبلاست، وأجنة خضرية، ويتم تجديد الكالوس بهدف تكوين نباتات كاملة بشكل مباشر أو غير مباشر، وقد تكون النباتات الناتجة عن تجديد الكالوس مشابهة للنبات الأم أو غير مشابهة للنبات الأم، وتعد تقانة زراعة الكالوس إحدى التقانات المستخدمة في تربية النبات والتحسين الوراثي، والتي يمكن الحصول بوساطتها على سلالات متباينة وراثيا عن النبات الأم. وقد تحمل السلالات الجديدة بعض الصفات المهمة في برنامج التربية للنبات المدروس، وهذا يؤدي إلى تحسين صفاته الكمية والنوعية. كما يمكن الحصول على سلالات مقاومة لبعض الأمراض والحشرات أو متحملة لبعض الإجهادات البيئية مثل تحمل الجفاف مثلا.
- سلالات Somaclones وهي عبارة عن سلالات تنشأ بزراعة النسج وقد تكون مشابهة للنبات الأم أو متباينة وراثيا عن النبات الأم.
- Somacolnal variation يقصد بها الحصول على سلالات متباينة وراثيا بدءاً من أجزاء نباتية مختلفة مثل الكالوس - خلايا - بروتوبلاست - حبوب لقاح - وجذور شعرية. ولا يمكن التحكم في هذه الحالة في التباينات الوراثية للسلالات المحدثة. يمكن أن تكون الاختلافات وراثية مؤقتة لا تلبث أن تزول بعد فترة من الزمن، وهي في هذه الحالة غير قابلة للتوريث. ويمكن ان تكون الاختلافات ثابتة وهي قابلة للتوريث للأجيال اللاحقة من النباتات.
الكالوس وأنواعه:
يظهر الكالوس عند تعرض الأنسجة النباتية للجروح والتقسيم، وينشأ من الأنسجة الميرستيمية أو الأنسجة النباتية التي لها قدرة على التمايز الرجعي مثل الأنسجة البارنشيمية.
والكالوس بالتعريف عبارة عن كتلة خلوية غير متمايزة لها القدرة على الانقسام وتنمو بشكل عشوائي. تختلف سرعة انقسام الكالوس ونموه بحسب النوع النباتي، وحسب مصدر الكالوس ونوعه وحسب الوسط المغذي ومكوناته، ويقسم الكالوس إلى عدة أنواع:
1- الكالوس الجنيني:
نوع من الكالوس يتميز بقدرته على تكوين الأجنة الخضرية، ويتصف بكونه سمني حبيبي وجلدي الملمس، ويعد أكثر أنواع الكالوس ثباتاً من الناحية الوراثية، أي نسبة التغيرات الوراثية في النباتات الناتجة عن الكالوس الجنيني منخفضة. ولهذا السبب يعد إكثار بالأجنة الخضرية إحدى طرائق الإكثار الخضري في العديد من الأنواع النباتية مثل النخيل.
2- الكالوس العضوي:
نوع من الكالوس الذي يتميز بقدرته على تكوين البراعم والجذور، وبالتالي إعطاء نباتات كاملة، ويتصف هذا الكالوس بتعدد ألوانه سمني مصفر، أو أخضر مصفر، وحبيباته أصغر حجماً من الكالوس الجنيني، وتكون سرعة نموه وتكاثره أكبر من الكالوس الجنيني، كما تكون نسبة التغيرات الوراثية في النباتات المتجددة منه كبيرة، لهذا السبب يستخدم هذا النوع من الكالوس لتكوين السلالات المتباينة وراثياً، ليصار إلى استخدامها في التحسين الوراثي للنباتات المدروسة.
3- الكالوس الهش:
وهو كالوس خفيف هش لونه سمني مسمر وفي أغلب الأحيان يصاب بظاهرة الشفافية والاسمرار، ويتحول إلى كالوس أسمر داكن اللون مائي الشكل، وليست له القدرة على التطور والتجديد. يمكن ان تتطور بعض خلاياه في بعض الأحيان لتكوين نوع آخر من الكالوس (عضوي أو جنيني). يهمل هذا النوع من الكالوس ولا يتابع نموه وإكثاره.
4- كالوس رخو مائي طري:
قد يكون أبيضاً أو سمنياً مسمرا. وهذا أيضاً لا يستطيع أن يتطور، وفي أغلب الأحيان يهمل.
ونشير إلى وجود عدة ألوان من الكالوس حسب النوع النباتي، وحسب الصبغات التي تتراكم فيها، نذكر منها على سبيل المثال الأخضر المصفر، الكالوس الأصفر المبيض، الكالوس الأحمر اللون أو السمني المحمر....
زراعة الكالوس:
أ- مزايا زراعة الكالوس:
1- تستخدم زراعة الكالوس بشكل أساسي في التحسين الوراثي للنباتات البستانية والحقلية. يتم الحصول على سلالات متباينة وراثيا والتي لها تطبيقات متعددة في تربية النبات نذكر منها على سبيل المثال لا الحصر:
- الحصول على سلالات متحملة للأمراض (الفطرية والبكتيرية والفيروسية)
- الحصول على سلالات متحملة أو مقاومة للنيماتودا.
- الحصول على سلالات متحملة للحشرات الضارة.
- الحصول على سلالات متحملة للإجهادات اللاحيوية مثل الجفاف والملوحة ......
- الحصول على سلالات متحملة لنوعية التربة مثل تحمل نسبة عالية من الكلس، او نوع التربة طينية أو خفيفة ....
- الحصول على سلالات تحمل بعض الصفات الوراثية التي تؤدي إلى زيادة الإنتاجية من الناحية الكمية والنوعية، مثل في النباتات الطبية زيادة المادة الفعالة وتحسين نوعيتها.....
2- تستخدم في الإكثار الخضري في بعض الأنواع عن طريق تكوين الأجنة الخضرية.
3- تستخدم زراعة الكالوس كمصدر هام للخلايا النباتية والبروتوبلاست.
4- تستخدم في إنتاج المواد الفعالة في بعض الأنواع النباتية الطبية.
تختلف أهداف زراعة الكالوس بحسب الأنواع النباتية، ففي النباتات الطبية والعطرية تهدف إلى إنتاج سلالات متباينة وذات نسبة عالية من المواد الفعالة، أو يمكن أن تحوي السلالات الجديدة مواد فعالة غير موجودة في النبات الأم.
ففي الزيتون مثلاً، تهدف زراعة الكالوس إلى إنتاج سلالات متباينة وراثياً لتحسين الإنتاجية ونوعية الزيت وكميته، وتحسين الأصناف وزيادة مقاومة أشجار الزيتون للأمراض والحشرات.
مثال: مرض التدهور البكتيري السريع في الزيتون Quick decline، يسببه نوع من البكتريا Xylela fastidiosa. وهو مرض خطير يؤدي إلى جفاف الأشجار وموتها بدءاً من النموات الغضة والأوراق الطرفية باتجاه الأفرع الهيكلية، والجذع، وفي النهاية تموت الأشجار، وينتقل هذا المرض بوساطة أدوات التطعيم والحشرات والنطاطات.
ينتشر هذا المرض حالياً بجنوب أوروبا وفي إيطاليا بالتحديد إذ قضى على عشرات الآلاف من أشجار الزيتون في جنوب إيطاليا عام 2013، وقد وصل هذا المرض إلى إيطاليا من أمريكا الجنوبية عن طريق شتلة بن مصابة بالبكتريا الممرضة، لا يوجد هذا المرض في القطر لحد الآن ولكن يتوجب أخذ الحيطة والحذر عن طريق فرض شروط صارمة لدخول غراس الزيتون والحمضيات إلى القطر مع التشديد في تطبيق قواعد الحجر الزراعي.
تلعب تقانات زراعة الأنسجة النباتية دوراً مهماً في مكافحة هذا المرض ومنع دخوله إلى القطر. ويمكن تحديد دور زراعة النسج بما يلي:
- عمل برنامج استنباط سلالات متباينة وراثياً متحملة لهذا المرض، عن طريق زراعة الكالوس.
- اعتماد تقانة زراعة النسج في نقل وتبادل المادة النباتية بين الدول.
- إكثار الأصناف المتحملة لهذا المرض بزراعة النسج الناتجة عن برامج التحسين الوراثي.
ب- مشاكل زراعة الكالوس:
لا تخلو زراعة الكالوس من بعض المشاكل والصعوبات وتوجد بعض النباتات التي ليس لها القدرة على تكوين نباتات كاملة من الكالوس نباتات كاملة من الكالوس.
- يتم الحصول على سلالات متباينة غير معروفة الصفات، وفي بعض الأحيان تحمل السلالات المتجددة صفات غير مرغوبة.
- يتم الحصول على طفرات غير مستقرة وغير ثابتة.
- يتوجب إخضاع السلالات المتباينة إلى عدة تجارب تقييم حقلي للتأكد من ثبات الصفات المنتخبة ولعدة سنوات.
- يمكن الحصول على تغييرات وراثية أثناء الإكثار أو تقييم السلالات.
كيف يتم الحصول على سلالات متباينة وراثيا بزراعة الكالوس:
يتم الحصول على سلالات متباينة وراثيا بوساطة زراعة الكالوس وفق الخطوات الآتية:
1- تكوين الكالوس العضوي:
يتم تعقيم أجزاء نباتية مختلفة وزراعتها بهدف الحصول على الكالوس العضوي (Organogenic callus)، ويمكن الحصول على الكالوس العضوي من أجزاء نباتية مختلفة من الأوراق - الجذور - القمم النامية – الكامبيوم - الأجزاء الزهرية والأجنة، كما يتم الحصول على الكالوس من زرع البروتوبلاست، والخلايا النباتية ضمن معلق خلوي، ومن زرع حبوب اللقاح والجذور الشعرية.
يجب دراسة تركيب الوسط المغذي المناسب والشروط المناسبة لتكوين الكالوس العضوي الذي له قدرة على التجديد وتكوين نباتات كاملة.
2- إكثار الكالوس العضوي:
يهدف إكثار الكالوس إلى زيادة كميته، وزيادة الخلط الوراثي لخلاياه، ويتوجب دراسة الوسط المغذي وشروط الإكثار التي تؤمن الحصول على أكبر كمية ممكنة من الكتلة الحية، وأعلى معدل لنمو وإكثار الكالوس على هذا المستوى يمكن عمل اختبارات لمدى تحمل الكالوس لبعض الإجهادات، مثل الجفاف والملوحة عن طريق إضافة عامل الإجهاد إلى الوسط المغذي.
3- تجديد الكالوس:
يتم نقل الكالوس العضوي إلى أوساط جديدة مناسبة لعملية التجديد أي تشكيل براعم وجذور وبالتالي الحصول على نباتات كاملة. يتم إكثار السلالات الجديدة المتشكلة حتى يتم الحصول على أعداد كافية من النباتات للتقييم واختيار المناسب منها، تعد هذه المرحلة أساسية في تكوين السلالات المتباينة وراثياً، تشكل عملية التجديد في بعض الأنواع النباتية معضلة كبيرة، فهي تحتاج كثير من العمل والجهد للحصول على نتيجة إيجابية. ففي كالوس البطاطا المجهد ملحيا تم تجريب أكثر من 40 وسط مغذي حتى تمكنا من الحصول على تشكيل نباتات كاملة من الكالوس (مصا وزملائها، 2018).
4- اختبار السلالات الجديدة:
يتم إكثار السلالات الجديدة الناتجة عن طريق التجديد، بهدف الحصول على أعداد كافية من كل سلالة للتقييم ومقارنتها من الناحية المورفولوجية والفيزيولوجية والوراثية مع النبات الأم الذي أخذت منه الأجزاء النباتية. يتم تحديد الصفات الجديدة التي تحملها السلالات الجديدة، واختيار التي تحمل بعض الصفات المهمة في برنامج التحسين الوراثي للنبات المدروس.
5- إكثار السلالات المنتخبة:
يتم إكثار السلالات التي تحمل صفات جديدة مهمة في برنامج التحسين الوراثي ليصار فيما بعد إلى تجريبها للتأكد من الثبات الوراثي للصفات الجديدة، ويتم اعتماد السلالات الجديدة وإكثارها، للحصول على أعداد كافية من النباتات للتجريب الحقلي قبل تحويلها إلى أصناف جديدة، يمكن استثمارها تجارياً.
العوامل المؤثرة في زراعة الكالوس:
توجد عوامل كثيرة تؤثر في زرع الكالوس وإنتاج سلالات متباينة وراثياً، وتقسم هذه العوامل إلى ثلاث مجموعات:
- عوامل فيزيولوجية: مثل طبيعة الأجزاء النباتية ومصدرها، عمر النبات الأم، النوع النباتي.
الفترة الزمنية المطبقة في إكثار الكالوس.
- عوامل تتعلق بالأوساط المغذية: التركيب المعدني، نوع الهرمونات النباتية المستخدمة وتراكيزها لكل مرحلة من مراحل زراعة الكالوس، طبيعة الوسط المغذي...
- عوامل تتعلق بالشروط الجوية المطبقة في غرف النمو مثل الحرارة الإضاءة والرطوبة.
يختلف تأثير العوامل باختلاف النوع النباتي، وباختلاف مرحلة الزرع فنفس العامل قد يكون له أثر إيجابي في مرحلة ويعطي أثر سلبي في مرحلة أخرى من زراعة الكالوس.
1- تأثير طبيعة الخزعات النباتية ومصدرها:
تختلف استجابة الخزعات النباتية لتكوين الكالوس بحسب النوع النباتي وحسب مصدرها لوحظ من خلال التجارب بأن الأجزاء النباتية الخالية من الأنسجة الميرستيمية، مثل الأوراق، والسلاميات لها القدرة على تكوين الكالوس وسلالات متباينة ومصدر للخلط الوراثي أكثر من الأجزاء النباتية الحاوية على أنسجة جنينية مثل البراعم والقمم النامية.
ويوضح الجدول (1) اختلاف تأثير الخزعات النباتية ومصدرها في مقدرة بعض الأنواع النباتية على تكوين سلالات متباينة.
ويوضح الشكل (1) تطور الميرستيم المزروع بالأنسجة في البطاطا للحصول على خزعات في طور الإكثار التي تم إكثارها لأخذ عينات ورقية منها لتكوين الكالوس كما هو موضح بالشكل (2).
جدول (1) تأثير الخزعات النباتية في تكوين سلالات متباينة


شكل (1) مراحل نمو القمم الميرستيمية لعينات البطاطا المزروعة بطول 300 ميكرون
الشكل (2) زراعة الكالوس (الكالوس العضوي ونبات متجدد في البطاطا)
2- تأثير الهرمونات النباتية في الوسط:
تلعب الهرمونات النباتية دوراً مهماً في تكوين وتجديد الكالوس، وفي زيادة الخلط الوراثي للسلالات الناتجة فقد لوحظ بأن الأوكسينات تؤثر بشكل مباشر في تكوين الكالوس وفي إكثاره ويختلف التأثير بحسب نوع الأوكسين وتركيزه.
لقد دلت التجارب بأن أفضل أوكسين لتكوين الكالوس، وفي زيادة الخلط الوراثي هو 2,4D. يختلف التركيز الأنسب بحسب الأنواع النباتية. يعمل هذا الأوكسين على زيادة إنتاج ال DNA في خلايا الكالوس، كما يزيد في عدد الكروموزومات في الخلايا، أي يسبب ظاهرة الـ Polyploidy لوحظ في نبات الفريز مثلا زيادة إنتاج الدنا وتضاعف عدد الصبغيات بسبب زيادة تركيز الـ 2,4,D في الوسط المغذي الخاص بتكوين الكالوس.
تلعب الهرمونات النباتية دوراً مهماً في تجديد الكالوس العضوي، على أن يكون التوازن الهرموني بين الأوكسينات والسيتوكينينات لصالح السيتوكينين، ويشجع السيتوكينين تكوين البراعم في الكالوس في مرحلة التجديد وإكثار العينات المتجددة. في حين الأوكسين يشجع تكوين الجذور. وتختلف نسب الهرمونات وتراكيزها وتوازناتها بحسب النوع النباتي ومصدر الكالوس في مرحلة التجديد.
3- تأثير الصنف:
يؤثر النوع النباتي والأصناف التابعة لنفس النوع بقدرتها على تكوين الكالوس وعلى تجديده كما يؤثر عامل الصنف على زيادة الخلط الوراثي في الكالوس دلت التجارب في الموز مثلا، بأن زيادة السيتوكينين في الوسط المغذي لم يؤثر في نسبة الخلط الوراثي لصنف كرافندیش Gravendish، بينما زادت نسبة الخلط الوراثي في الصنف الموز وليامس باستخدام نفس التركيز من السيتوكينين.
4- تأثير فترة الزراعة وعدد مرات النقل:
تلعب فترة زراعة الكالوس دوراً مهماً في زيادة الكتلة الحية، وفي زيادة الخلط الوراثي في خلاياه. كما يؤثر عدد مرات النقل في الثبات الوراثي للكالوس وفي مقدرته على التجديد. وكلما زادت الفترة الزمنية أو عدد مرات النقل كلما زادت نسبة التغير الوراثي، كما تقل قدرته على التجديد وتكوين نباتات كاملة. فقد لوحظ في حال الكالوس الجنيني عند نقله لفترة زمنية طويلة يفقد قدرته على التجديد وعلى تكوين أجنة خضرية. وقد لوحظت هذه الظاهرة في عدة أنواع نباتية مثل التبغ والجذر والخس.... (1982 ,Margara).
وقد لوحظت نفس الظاهرة في النخيل، وقد قامت الباحثة Zaid عام 1989 بعمل دراسة تفصيلية حول تدهور كالوس النخيل، حيث لاحظت في بداية الأمر البنية الحبيبية للكالوس وقدرته الكبيرة على تكوين الأجنة الخضرية. يبدأ بعد فترة من الزمن بسبب النقل المتكرر لفترة طويلة نسبيا بفقدان قدرته على تكوين الأجنة الخضرية بشكل تدريجي. ويلاحظ تغييرات على المستوى التشريحي للكالوس الجنيني. يظهر تهشم الطبقة الخارجية للكالوس ويتحول من الشكل الحبيبي إلى الشكل الرخو، وتتراكم في انسجة الخلايا بعض المركبات الفينولية، ويأخذ اللون الأسمر ويفقد قدرته على الانقسام وينتهي الأمر بتدهور الكالوس (المعري، 1995).
التغيرات الوراثية التي تحدث في النباتات المتجددة من الكالوس:
تحدث تغييرات كمية ونوعية على مستوى جينوم خلايا الكالوس، أثناء مرحلة إكثارها وتجديدها لتعطي سلالات متباينة وراثياً.
1- وقد يحدث التغييرات التالية والتي يمكن إيجازها بالآتي:
- تغير في عدد الصبغيات بسبب زيادة اصطناع الـ DNA.
- تغير في بنية الصبغيات.
- اختلاف في ترتيب أو تسلسل المورثات على مستوى الصبغيات.
- نقص جزء من الكروموزوم، او تنشيط بعض المورثات الصامتة مما يؤدي إلى تغيير في وظيفة الجينات المتنحية عندما تكون الخلايا في مرحلة وحيدة الصيغة الصبغية أي يلاحظ عدم انتظام في وظيفة الصبغيات.
- تغييرات في إنتاج الدنا في النواة مما يؤدي إلى زيادة عدد الصبغيات أو تضاعفها.
- حدوث طفرات أو اختلافات وراثية على مستوى جينوم الكلوروبلاست أو الميتوكوندري، وذلك عن طريق تنشيط بعض المورثات أو تثبيط عمل مورثات أخرى، بالإضافة إلى تنشيط تكوين الـ DNA.
- تغير في التعبير الجيني في السلالات المتباينة وراثيا، بسبب التغير في بنية الدنا من خلال عملية ال DNA Methylation أي إضافة جذر الميتيل إلى السيتوزين أو الآدنين في النيكليوتيدات التي تشكل بنية الدنا. وقد لوحظت هذه الظاهرة أي إضافة جذر الميتيل في العديد من الطفرات المحدثة في بعض الأنواع النباتية مثل العنب – التفاح - نخيل الزيت.
2- أسباب حدوث التغييرات الوراثية بزراعة الأنسجة النباتية:
توجد مسببات كثيرة تسبب حدوث الطفرات الوراثية على مستوى الكالوس. ويمكن إيجازها بالآتي:
أ- الخزعات النباتية المستخدمة، نوعها وطريقة تحضيرها طريقة التعقيم الجروح الزائدة تساعد في حدوث تغييرات وراثية.
ب- الأوساط المغذية وتركيبها من المحلول المعدني والهرمونات النباتية. تحدث تغيرات وراثية عند تعريض الخزعات النباتية والكالوس للإجهادات مثل تراكيز عالية من الهرمونات، تراكيز ملحية عالية، ومعاملات جفاف.
ت- تعريض الخزعات نباتية إلى شروط إجهاد مناخية مثل درجات حرارة عالية، إضاءة شديدة، نقص أوكسجين كل هذه العوامل يمكن أن تحدث تغييرات وراثية على مستوى الخزعات أو على مستوى الكالوس.
3- آلية تشكل السلالات المتباينة وراثيا والمحدثة من الكالوس:
عند تعرض الخزعات النباتية او الكالوس إلى إحدى مسببات السابقة التي تحدث تغييراً في التركيب الوراثي في النباتات المتجددة من الكالوس. تسبب حدوث إجهاد أكسدة على مستوى الخلايا، وهذا بدوره يسبب تكون جذور حرة في الخلايا التي تحدث تغييرات وراثية.
تظهر عدة أشكال من الجذور الحرة مثل:
- سوبر أوكسيد Superoxide وهذا يحدث تغير عن طريق إحداث DNA Methylation
- بيروكسيد الهيدروجين Hydrogene peroxide، الذي يسبب تغير في عدد الكروموزومات.
- الهيدروكسيل Hydroxyl تحدث تبدلات في موضع الجينات وترتيبها على الصبغيات.
- الكوكسيل ALKOXIL والبيروكسيل Peroxyl وهذين المركبين يحدثوا تغيير في بنية الدنا زيادة أو نقصان.
تحدث الجذور الحرة تغييرات وراثية مما يؤدي إلى ظهور طفرات في العينات النباتية المزروعة وخاصة الكالوس مما يتسبب بتكوين سلالات متباينة وراثياً بعد التجديد.
تقييم السلالات المتباينة وراثياً:
يتم تقييم السلالات المحدثة من الكالوس والمتباينة بهدف انتخاب السلالات التي تحمل صفات مهمة جديدة لاعتمادها واستثمارها في المجال الإنتاجي. يعتمد في التقييم المخبري والحقلي المعايير التالية:
1- المعايير المورفولوجية:
مثل الشكل - اللون - طبيعة النمو - ارتفاع النبات - شكل الأوراق - سماكة الأوراق شكل الثمار وحجمها ....
2- المعايير الفيزيولوجية:
قوة نمو النبات - الاصطناع الضوئي وشدته - مدى تحمل السلالات المدروسة للإجهادات الحيوية واللاحيوية - كثافة المسامات - حجم المسطح الورقي ......
3- المعايير الزراعية والإنتاجية:
الإزهار - القدرة على التلقيح - إنتاجية النبات من الثمار - نوعية الثمار المنتجة ....
4- المعايير السيتولوجية:
عدد الكروموزومات في السلالات - الصيغة الصبغية ثنائية أو ثلاثية أو رباعية كثافة السيتوبلاسم في الخلايا - حجم الخلايا....
5- المعايير البيوكيميائية:
محتوى الثمار من المركبات العضوية مثل البروتينات - الكربوهيدرات - الدهون - نسبة الحموضة - النشاط الأنزيمي - محتوى الثمار من الفيتامينات أو المواد الطبية الفعالة.....
6- المعايير الجزيئية:
ويقصد بها دراسة الاختلافات الوراثية بين السلالات على مستوى الدنا، باستخدام تقانات المؤشرات الجزيئية مثل RAPD – AFLP - SSR-ISSR ...
Randomly amplified polymorphic DNA : RAPD: استخدمت هذه التقانة في الكشف عن السلالات المتباينة وراثيا في الدراق والبرتقال والزيتون.
Amplified fragment length polymorphism : AFLP : استخدمت في الكشف عن السلالات المتباينة في الكيوي وفي العنب.
Simple sequence repeat : SSR : استخدمت في الأكيدنيا.
Inter simple sequence repeat : ISSR : استخدمت أيضا في دراسة التباينات الوراثية في السلالات المحدثة في الأكيدنيا.
يلجأ بعض الباحثين لاستخدام أكثر من طريقة للتأكد من الاختلافات الوراثية في السلالات المدروسة. وقد استعملت تقانة الـ RAPD مع تقانة الـ ISSR في دراسة التباينات الوراثية في ( الأكي دنيا ).
إنتاج بعض السلالات ذات الأهمية الاقتصادية:
تم إنتاج العديد من السلالات ذات الأهمية الزراعية، باستخدام تقانة زراعة الكالوس، في بعض الأنواع البستانية. قسم من هذه السلالات أثبت مقاومة لبعض الأمراض والنيماتودا. كما تم الحصول على بعض السلالات المتحملة للملوحة ودرجات الحرارة المرتفعة. وقسم من السلالات اعطى زيادة في الانتاجية كما زاد من نوعية الثمار المنتجة. ويوضح الجدول (2) بعض السلالات المنتخبة ذات الاهمية الاقتصادية في بعض المحاصيل البستانية.
جدول (2) انتخاب سلالات ذات اهمية زراعية بوساطة زراعة الكالوس

إنتاج مواد فعالة بزراعة الكالوس:
تمثل النباتات الطبية مصادر مهمة للمواد الفعالة التي تدخل بصناعة الأدوية. تستخدم تقانة زراعة الكالوس في التحسين الوراثي للنباتات الطبية، كما تستخدم لإنتاج المواد الفعالة بدءاً من الكالوس. وقد استخدمت في إنتاج العديد من المواد الفعالة. ففي نبات Ocimum granisimum قد تم زراعة عقل صغير في وسط مغذي لتكوين وإكثار الكالوس. وقد تم الحصول على الكالوس من الأوراق، نقل الكالوس لوسط جديد لإنتاج روزمارينيك أسيد Rosmarinic acid، وهو مضاد اكسدة ويستخدم طبيا كمضاد للالتهابات البكتيرية والفيروسية، وقد تم استخلاص هذا المركب من الوسط المزروع به الكالوس Savanthi et al., 2016 ).
مثال على زراعة الكالوس:
في الليمون المخرفش Citrus jambhiri: يستخدم هذا النوع من الحمضيات كأصل جيد لليمون والبرتقال في الهند، وقد تم الحصول على سلالات بنسبة عالية من الكالوس في هذا النوع وفق الخطوات الآتية:
- أخذت بذور من الليمون المخرفش وزرعت في وسط مغذي بعد تعقيمها وضعت في الظلام حتى الإنبات والحصول على بادرات صغيرة.
- أخذت الفلقات وزرعت في وسط يحوي محلول موراشيج وسكوغ مضاف له 2 مغ/ل من الـD,2,4 0.75 + مغ/ل من السيتوكينين بنزيل آمينو بيورين. بلغت نسبة العينات التي كونت الكالوس 83%. وكان الكالوس سمني مخضر وقسم منه أخضر واضح.
- تم إكثار الكالوس لعدة مرات ثم نقل إلى وسط تجديد يحوي MS أضيف له 3 مغ/ل من الـ BAP وبلغت نسبة التجديد 87.5%.
- نقلت النموات المتجددة إلى وسط تجذير يحوي أوكسين بمعدل 0.5 مغ/ل من الIBA. بلغت نسبة التجذير 91 %.
- تم تقسية النباتات المتجددة ووصلت نسبة نجاح التقسية أكثر من 67% (Singh et al.,2011).
ولابد من الذكر أخيرا بان الكالوس في الليمون المخرفش، احتفظ بقدرته على التجديد لأكثر من 420 يوما، ولكن نسبة التجديد انخفضت نسبيا الى 58%.
في هذا المثال، تم وضع بروتوكول جيد مع نسبة نجاح عالية على تجديد نباتات كاملة من الكالوس. وهذا البروتوكول يمكن استخدامه في الكالوس المعدل وراثيا للحصول على نباتات معدلة وراثيا.
الاكثر قراءة في الزراعة النسيجية
اخر الاخبار
اخبار العتبة العباسية المقدسة
الآخبار الصحية

قسم الشؤون الفكرية يصدر كتاباً يوثق تاريخ السدانة في العتبة العباسية المقدسة
"المهمة".. إصدار قصصي يوثّق القصص الفائزة في مسابقة فتوى الدفاع المقدسة للقصة القصيرة
(نوافذ).. إصدار أدبي يوثق القصص الفائزة في مسابقة الإمام العسكري (عليه السلام)